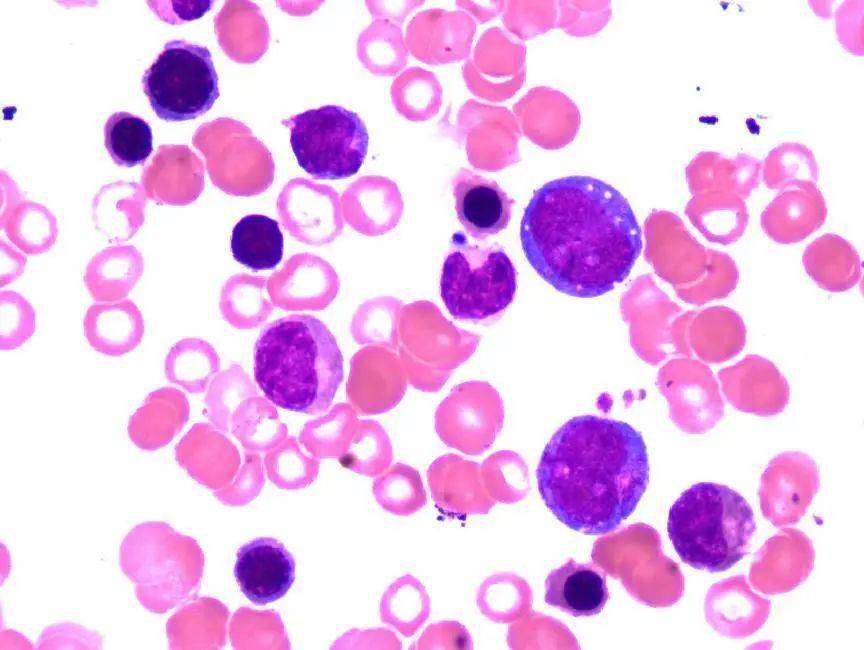

单核细胞增多有什么影响 单核细胞增多症要紧吗
单核细胞增多有什么影响 单核细胞增多症要紧吗

作者 | 单鹏
单位 | 中国科学技术大学附属第一医院(安徽省立医院)南区
前 言
提到单核细胞增多,一般作何思考呢?生理性增多?结核感染?急性感染恢复期?亦或是原始幼稚阶段明显增多的白血病?笔者最近遇到了一例有意思的病例介绍如下。
案例经过
首先回顾一下病史:
54岁男性患者,1月前,无明显诱因下出现发热伴乏力、腹胀,多于午后发热,最高体温39.6℃,不伴有腹泻、腹痛、咳嗽咳痰等。就诊于当地诊所,予以抗感染对症治疗后体温下降。随后多次因反复发热就诊。外院行CT检查,提示两肺纤维灶,胸腔积液,盆腔大量积液,多发淋巴结肿大,脾大,脾梗死。予以抗感染,利尿,腹腔积液引流对症治疗后体温可降至正常但仍反复发热。
患者体格检查:神清,精神欠佳,巩膜无黄染,全身皮肤、粘膜未见瘀点瘀斑,右侧颌下触及肿大淋巴结,双肺呼吸音粗,未闻及明显的干、湿啰音,心律齐,未闻及明显杂音。腹部膨隆,腹腔置管引流在位,移动性浊音(+),胸骨无压痛,腹部柔软,无压痛、反跳痛,肝脾肋下未及,双下肢无浮肿。
那么结合病史、体格检查及CT,需要考虑的初步诊断包括多发淋巴结增大、发热、多浆膜腔积液、脾大。接下来结合相关检查进一步分析。
案例分析
患者首次血常规结果如下:

血常规结果显示白细胞数明显增高,单核细胞比例及绝对值明显增高,网织红细胞比例及绝对值均明显增高。是感染还是血液系统疾病呢。

外周血涂片(10*100)
涂片示单核细胞比例增高,并且为成熟的单核细胞。分类可见幼粒、幼红细胞。
接下来看看骨髓细胞形态(10*10):

低倍镜下可以看到骨髓增生是明显活跃的,符合外周血网织红细胞比例明显增高的表现,接下来时换到油镜视野(10*100):

可以看到骨髓中有一类原幼细胞,胞体偏大,类圆形,胞浆丰富,深蓝色,有颗粒,染色质细,核仁明显,考虑原始、幼稚单核细胞,此类细胞比例约占有核细胞8%,仅看骨髓细胞形态,考虑MDS?MDS/MPN?还是其他骨髓增殖性疾病呢?细胞形态报告如下:

结合患者单核细胞比例及绝对值明显增高,网织红细胞比例也明显增高,脾大,我们给出诊断意见是符合CMML骨髓象。
接下来看一下流式细胞学结果:

结合目前结果,考虑CMML应该问题不大了。
过了一周之后MPN基因突变检测出来了。

结果显示有JAK2V617F阳性。
骨髓病理如下:

病理结果可见网状纤维染色为2级,是符合骨髓纤维化的。
结合患者骨髓所有检查结果,最终临床诊断考虑此例为骨髓纤维化伴单核细胞增多。
案例总结
我们先来复习一下MDS、CMML和PMF的相关诊断标准:
01MDS诊断标准:
1.必备条件(下面两个条件必须同时具备,缺一不可)
(1)下列细胞系别中一系或多系持续性减少(≥6个月):红细胞(Hb<110g/L):中性粒细胞(ANC<1.5×109/L):巨核细胞系(PLT<100×109/L),
(2)排除可以成为血细胞减少/发育异常原发原因的所有其他造血组织或非造血组织疾病。
2.确定条件
(1)骨髓涂片中红细胞系、中性粒细胞系或巨核细胞系任何一系细胞中至少10%有发育异常,或环状铁粒幼红细胞>15%,
(2)骨髓涂片中原始细胞占5%~19%,
(3)典型的染色体异常(常规核型分析法或FISH),
3.辅助条件(指符合“1”而不符合“2”的患者,而且表现其他方面的典型临床特征,如输血依赖性大细胞贫血),
(1)流式细胞术检测骨髓细胞表型,明确显示有单克隆红系和/或髓系细胞组群,
(2)HUMARA分析、基因芯片谱型或基因点突变分析(如RAS突交)显示有单克隆细胞组群的明确分子征象,
(3)CFU检测骨髓和/或循环中祖细胞集落(±集丛)形成显著而持久性减少。
02CMML诊断标准:
1.外周血持续性单核细胞增多≥1×109/L,伴单核细胞在白细胞分类中的比例≥10%。
2.外周血或骨髓中原始细胞(包括原始粒细胞和原幼单核细胞)<20%。
3.不符合BCR-ABL1+CML、PMF、PV或ET的诊断标准。
4.无PDGFRA、PDGFRB或FGFR1重排,或PCMI-JAK2(特别对伴嗜酸粒细胞增多的病例需要进行基因检测,排除阳性者)。
5.髓系细胞一系或多系发育异常。如无发育异常或极轻微,符合以下条件仍可诊断CMML:造血细胞存在获得性克隆性细胞或分子遗传学异常;或单核细胞增多持续至少3个月,并除外引起单核细胞增多的其他原因。
03原发性骨髓纤维化,明显期诊断标准:
诊断需符合3条主要标准和至少1条次要标准:
主要标准
1.有巨核细胞增生和异型巨核细胞,常伴有网状纤维或胶原纤维增多(MF-2或MF-3)
2.不能满足真性红细胞增多症、慢性粒细胞白血病(BCR-ABL融合基因阳性,骨髓增生异常综合征(无粒系和红系病态造血)或其他髓系肿瘤的WHO诊断标准
3.有JAK2、CALR或MPL突交,或无这些突交但有其他克隆性标志,或无反应性骨髓纤维化证据。
次要标准
1.非合并疾病导致的贫血
2.WBC> 11X109/L
3.可触及的牌大
4.幼粒幼红血象
5.血清乳酸脱氢的水平增高
我们分析一下该患者首次血常规结果,白细胞增多,贫血,网织红细胞增高,并且白细胞中单核细胞比例和绝对值明显增高,涂片幼粒、幼红血象,有经验的老师能想到会不会是MDS/MPN中的CMML呢。分析患者骨髓细胞形态,原始细胞增多,占到8%,粒系、红系、巨核系比例相对正常,从形态看,首先我们考虑MDS/MPN中的CMML-1是没有问题的。那么接下来就是等着相关的基因检测和骨髓病理结果综合分析。
在《血液病及疗效标准》关于CMML诊断的评论中有这么一段话:“MPN的其他亚型可伴有单核细胞增多,或在疾病进程中出现单核细胞增多,与CMML类似,但这种情况并不常见。有MPN病史、骨髓具有MPN特点和/或有MPN相关基因突变(JAK2、CALR、或MPL)倾向于诊断MPN伴单核细胞增多,而非CMML。”
这段话在该病例上也很好地体现出来了。
这个病例的转折点在于MPN基因突变检测中检测出来了JAK2V617F,我们知道这个基因是属于骨髓增殖性疾病中比较常见的基因。回过头我们再重新整理思路,就能拨开迷雾恍然大悟,原来我们被单核细胞蒙蔽了双眼,通过基因检测一针见血的将诊断明确。从中我们也能体会到骨髓形态和综合诊断的魅力,那么亲爱的读者老师们您觉得这是不是单核细胞的错呢?
参考文献
《血液病诊断及疗效标准》第四版沈悌等主编
-
- 我的前半生里罗子君说的最经典的一句话是 我的前半生罗子君内心独白
-
2024-01-17 01:11:05
-
- 学习分享|文具安利第二波!你们要的本子大赏来啦
-
2024-01-17 01:08:51
-
- 播放9月5日 9.5日
-
2024-01-17 01:06:36
-
- 不要再说重庆原本就是四川的了,历史上两者到底是什么关系呢?
-
2024-01-17 01:04:21
-
- 福彩3d2021058期字谜 福彩3d2021195期字谜
-
2024-01-16 13:21:56
-
- 香烟最贵排名前十名烟 香烟最贵排名前十品牌
-
2024-01-16 13:19:41
-
- 去哪儿wang 去哪儿官网
-
2024-01-16 13:17:26
-
- 广西桂林成为全国第五个直辖市,可行性有多大,会带来哪些影响?
-
2024-01-16 13:15:12
-
- 亥猪后面是什么生肖 亥巳相合吗
-
2024-01-16 13:12:57
-
- 封闭减肥训练营一个月能瘦多少 封闭式减肥营怎么样
-
2024-01-16 13:10:42
-
- 剧本杀管理系统开发 剧本杀管理系统研究背景和目的
-
2024-01-16 13:08:27
-
- 流食是啥意思网络用语 100种流食食谱大全
-
2024-01-16 13:06:12
-
- 小狗已经开始在家随地大小便,怎么教育它 小狗已经开始在家随地大小便,怎么教育
-
2024-01-16 13:03:57
-
- 史上最全by用法考察
-
2024-01-16 13:01:43
-
- 脘说文解字 皖的金文
-
2024-01-11 21:27:19
-
- 俗话说七尺男儿是多高 常说的七尺男儿是多高
-
2024-01-11 21:25:05
-
- 古琴越贵越好吗 古琴贵的和便宜的区别在哪
-
2024-01-11 21:22:50
-
- 公马和母马是怎么繁衍后代的,看完你就知道了
-
2024-01-11 21:20:35
-
- 当今中东地区五大强国:土耳其、以色列、埃及、伊朗及沙特
-
2024-01-11 21:18:21
-
- 注意!退烧药在短时间内不可超过几天 注意!退烧药在短时间内不可超过多久
-
2024-01-11 21:16:06



骨灰盒下葬红布要不要拿掉(骨灰盒下葬需要盖布吗)
大师王林风流往事,为几十名女星“开光”,李冰冰周迅都是座上宾
海角论坛网页版怎么进入
《姓氏起源》之—吴姓,源出后稷,姬姓同宗,吴国贤人季札为远祖
真黑便与假黑便图片对比区别 真黑便与假黑便图片绿色
未来10大暴利种植药材 :十种不愁销路的中药材品种
卧底3与狼共舞剧情简介 成功铲除制毒团伙的故事
太原头脑哪家最美味?老字号十家店铺全攻略!
成都黑帽吴施蒙9段视频贴吧的简单介绍
「原创」短文|“东北大老娘们”的含义